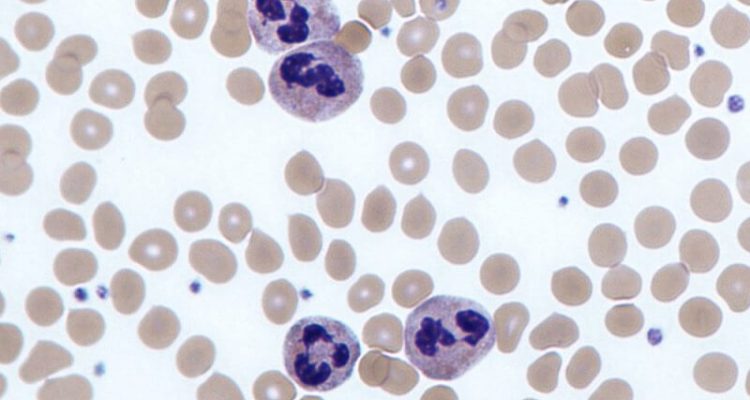

Через рідкісну генетичну мутацію люди з дефіцитом адгезії лейкоцитів 1 типу (ДАЛ1) часто стикаються з важким перебігом бактеріальних інфекцій і захворювань ясен. Найчастіше зуби губляться вже в ранньому віці.
У новому дослідженні, опублікованому в Journal of leukocyte Biology, вчені зі школи стоматології при Університеті Пенсільванії визначили нову стратегію для усунення першопричини симптомів у пацієнтів з ДАЛ1. Для зменшення запалення на тлі нестачі нейтрофілів вчені використовували молекулу, що імітує еффероцітоз. В результаті лікування у тварин зі змодельованим ДАЛ1, не тільки запобігалося запалення ясен, але і втрата зубної кістки. Кістки і здорові тканини регенерували швидше.
“Це лікування може використовуватися не тільки для ДАЛ1”, – зазначає Джордж Гаджишенгалліс, старший автор роботи і професор в школі стоматології при Університеті Пенсільванії. “Існують і інші стани, при яких ми спостерігаємо погане накопичення або відсутність нейтрофілів в яснах, наприклад, при синдромі Папійона-Лефевра або синдромі Чедіака-Хігасі. Є також кілька станів, що викликають нейтропенію, при якій кількість нейтрофілів низька, наприклад, ВІЛ або ракові пухлини. Лікування, що імітує ефероцітоз може бути корисним і для них”.